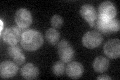
YBR110W
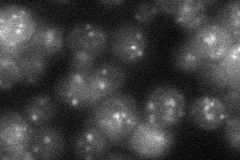
YBR110W
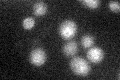
YBR110W

View description
Mannosyltransferase, involved in asparagine-linked glycosylation in the endoplasmic reticulum (ER); essential for viability, mutation is functionally complemented by human ortholog
Localization:
Intensity:
Fold change:
Significance:
-
C’ GFP library in SD
ER26.44 -
N' NOP1pr-GFP in SD

punctate73.576 -
N' TEF2pr-mCherry in SD

punctate132.793 -
N' NATIVEpr-GFP in SD
punctate25.4456 -
N' TEF2pr-VC and Cyto-VN in SD

below threshold24.3267 -
C’ GFP library in SD+DTT

ER28.631.08No -
C’ GFP library in SD+H2O2

ER27.641.04No -
C’ GFP library in Starvation Media
ER29.31.1No -
C’ GFP library on the background of Pup2-DaMP

ER -
C’ GFP library on the background of CCT mutant

ER24.13540.912647No
